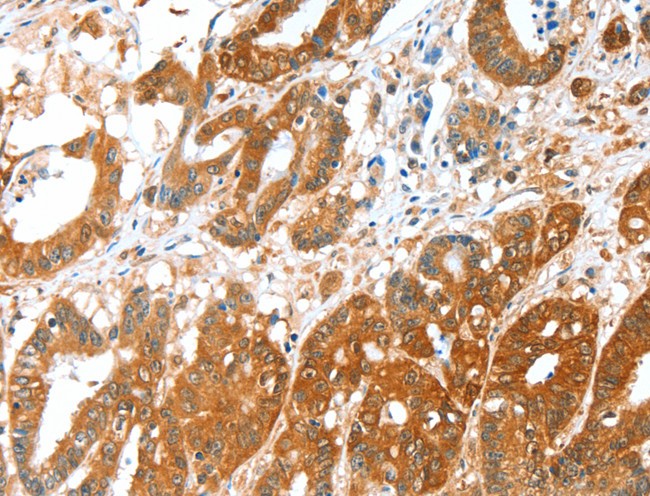
product-image-AAA167956_IHC13.jpg
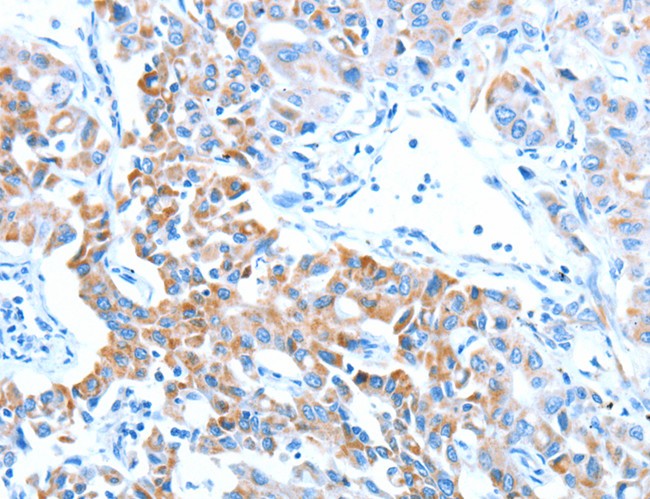
product-image-AAA170371_IHC13.jpg

Succinate-semialdehyde dehydrogenase Recombinant Protein | ALDH5A1 recombinant protein
Recombinant Human Succinate-semialdehyde dehydrogenase, mitochondrial
Gene Names
ALDH5A1; SSDH; SSADH
Purity
Greater or equal to 85% purity as determined by SDS-PAGE.
Synonyms
Succinate-semialdehyde dehydrogenase; N/A; Recombinant Human Succinate-semialdehyde dehydrogenase, mitochondrial; Aldehyde dehydrogenase family 5 member A1; A1NAD(+)-dependent succinic semialdehyde dehydrogenase; ALDH5A1 recombinant protein
Host
E Coli or Yeast or Baculovirus or Mammalian Cell
Purity/Purification
Greater or equal to 85% purity as determined by SDS-PAGE.
Form/Format
Lyophilized or liquid (Format to be determined during the manufacturing process)
Sequence Positions
48-535. Full Length of Mature Protein
Sequence
AGRLAGLSAALLRTDSFVGGRWLPAAATFPVQDPASGAALGMVADCGVREARAAVRAAYEAFCRWREVSAKERSSLLRKWYNLMIQNKDDLARIITAESGKPLKEAHGEILYSAFFLEWFSEEARRVYGDIIHTPAKDRRALVLKQPIGVAAVITPWNFPSAMITRKVGAALAAGCTVVVKPAEDTPFSALALAELASQAGIPSGVYNVIPCSRKNAKEVGEAICTDPLVSKISFTGSTTTGKILLHHAANSVKRVSMELGGLAPFIVFDSANVDQAVAGAMASKFRNTGQTCVCSNQFLVQRGIHDAFVKAFAEAMKKNLRVGNGFEEGTTQGPLINEKAVEKVEKQVNDAVSKGATVVTGGKRHQLGKNFFEPTLLCNVTQDMLCTHEETFGPLAPVIKFDTEEEAIAIANAADVGLAGYFYSQDPAQIWRVAEQLEVGMVGVNEGLISSVECPFGGVKQSGLGREGSKYGIDEYLELKYVCYGGL
Preparation and Storage
Store at -20 degree C, for extended storage, conserve at -20 degree C or -80 degree C.
Related Product Information for ALDH5A1 recombinant protein
Catalyzes one step in the degradation of the inhibitory neurotransmitter gamma-aminobutyric acid (GABA).
Product Categories/Family for ALDH5A1 recombinant protein
References
Two exon-skipping mutations as the molecular basis of succinic semialdehyde dehydrogenase deficiency (4-hydroxybutyric aciduria) .Chambliss K.L., Hinson D.D., Trettel F., Malaspina P., Novelletto A., Jakobs C., Gibson K.M.Am. J. Hum. Genet. 63:399-408(1998) Structure of human succinic semialdehyde dehydrogenase gene identification of promoter region and alternatively processed isoforms.Blasi P., Boyl P.P., Ledda M., Novelletto A., Gibson K.M., Jakobs C., Hogema B., Akaboshi S., Loreni F., Malaspina P.Mol. Genet. Metab. 76:348-362(2002) Complete sequencing and characterization of 21,243 full-length human cDNAs.Ota T., Suzuki Y., Nishikawa T., Otsuki T., Sugiyama T., Irie R., Wakamatsu A., Hayashi K., Sato H., Nagai K., Kimura K., Makita H., Sekine M., Obayashi M., Nishi T., Shibahara T., Tanaka T., Ishii S., Yamamoto J., Saito K., Kawai Y., Isono Y., Nakamura Y., Nagahari K., Murakami K., Yasuda T., Iwayanagi T., Wagatsuma M., Shiratori A., Sudo H., Hosoiri T., Kaku Y., Kodaira H., Kondo H., Sugawara M., Takahashi M., Kanda K., Yokoi T., Furuya T., Kikkawa E., Omura Y., Abe K., Kamihara K., Katsuta N., Sato K., Tanikawa M., Yamazaki M., Ninomiya K., Ishibashi T., Yamashita H., Murakawa K., Fujimori K., Tanai H., Kimata M., Watanabe M., Hiraoka S., Chiba Y., Ishida S., Ono Y., Takiguchi S., Watanabe S., Yosida M., Hotuta T., Kusano J., Kanehori K., Takahashi-Fujii A., Hara H., Tanase T.-O., Nomura Y., Togiya S., Komai F., Hara R., Takeuchi K., Arita M., Imose N., Musashino K., Yuuki H., Oshima A., Sasaki N., Aotsuka S., Yoshikawa Y., Matsunawa H., Ichihara T., Shiohata N., Sano S., Moriya S., Momiyama H., Satoh N., Takami S., Terashima Y., Suzuki O., Nakagawa S., Senoh A., Mizoguchi H., Goto Y., Shimizu F., Wakebe H., Hishigaki H., Watanabe T., Sugiyama A., Takemoto M., Kawakami B., Yamazaki M., Watanabe K., Kumagai A., Itakura S., Fukuzumi Y., Fujimori Y., Komiyama M., Tashiro H., Tanigami A., Fujiwara T., Ono T., Yamada K., Fujii Y., Ozaki K., Hirao M., Ohmori Y., Kawabata A., Hikiji T., Kobatake N., Inagaki H., Ikema Y., Okamoto S., Okitani R., Kawakami T., Noguchi S., Itoh T., Shigeta K., Senba T., Matsumura K., Nakajima Y., Mizuno T., Morinaga M., Sasaki M., Togashi T., Oyama M., Hata H., Watanabe M., Komatsu T., Mizushima-Sugano J., Satoh T., Shirai Y., Takahashi Y., Nakagawa K., Okumura K., Nagase T., Nomura N., Kikuchi H., Masuho Y., Yamashita R., Nakai K., Yada T., Nakamura Y., Ohara O., Isogai T., Sugano S.Nat. Genet. 36:40-45(2004) The DNA sequence and analysis of human chromosome 6.Mungall A.J., Palmer S.A., Sims S.K., Edwards C.A., Ashurst J.L., Wilming L., Jones M.C., Horton R., Hunt S.E., Scott C.E., Gilbert J.G.R., Clamp M.E., Bethel G., Milne S., Ainscough R., Almeida J.P., Ambrose K.D., Andrews T.D., Ashwell R.I.S., Babbage A.K., Bagguley C.L., Bailey J., Banerjee R., Barker D.J., Barlow K.F., Bates K., Beare D.M., Beasley H., Beasley O., Bird C.P., Blakey S.E., Bray-Allen S., Brook J., Brown A.J., Brown J.Y., Burford D.C., Burrill W., Burton J., Carder C., Carter N.P., Chapman J.C., Clark S.Y., Clark G., Clee C.M., Clegg S., Cobley V., Collier R.E., Collins J.E., Colman L.K., Corby N.R., Coville G.J., Culley K.M., Dhami P., Davies J., Dunn M., Earthrowl M.E., Ellington A.E., Evans K.A., Faulkner L., Francis M.D., Frankish A., Frankland J., French L., Garner P., Garnett J., Ghori M.J., Gilby L.M., Gillson C.J., Glithero R.J., Grafham D.V., Grant M., Gribble S., Griffiths C., Griffiths M.N.D., Hall R., Halls K.S., Hammond S., Harley J.L., Hart E.A., Heath P.D., Heathcott R., Holmes S.J., Howden P.J., Howe K.L., Howell G.R., Huckle E., Humphray S.J., Humphries M.D., Hunt A.R., Johnson C.M., Joy A.A., Kay M., Keenan S.J., Kimberley A.M., King A., Laird G.K., Langford C., Lawlor S., Leongamornlert D.A., Leversha M., Lloyd C.R., Lloyd D.M., Loveland J.E., Lovell J., Martin S., Mashreghi-Mohammadi M., Maslen G.L., Matthews L., McCann O.T., McLaren S.J., McLay K., McMurray A., Moore M.J.F., Mullikin J.C., Niblett D., Nickerson T., Novik K.L., Oliver K., Overton-Larty E.K., Parker A., Patel R., Pearce A.V., Peck A.I., Phillimore B.J.C.T., Phillips S., Plumb R.W., Porter K.M., Ramsey Y., Ranby S.A., Rice C.M., Ross M.T., Searle S.M., Sehra H.K., Sheridan E., Skuce C.D., Smith S., Smith M., Spraggon L., Squares S.L., Steward C.A., Sycamore N., Tamlyn-Hall G., Tester J., Theaker A.J., Thomas D.W., Thorpe A., Tracey A., Tromans A., Tubby B., Wall M., Wallis J.M., West A.P., White S.S., Whitehead S.L., Whittaker H., Wild A., Willey D.J., Wilmer T.E., Wood J.M., Wray P.W., Wyatt J.C., Young L., Younger R.M., Bentley D.R., Coulson A., Durbin R.M., Hubbard T., Sulston J.E., Dunham I., Rogers J., Beck S.Nature 425:805-811(2003) Mural R.J., Istrail S., Sutton G., Florea L., Halpern A.L., Mobarry C.M., Lippert R., Walenz B., Shatkay H., Dew I., Miller J.R., Flanigan M.J., Edwards N.J., Bolanos R., Fasulo D., Halldorsson B.V., Hannenhalli S., Turner R., Yooseph S., Lu F., Nusskern D.R., Shue B.C., Zheng X.H., Zhong F., Delcher A.L., Huson D.H., Kravitz S.A., Mouchard L., Reinert K., Remington K.A., Clark A.G., Waterman M.S., Eichler E.E., Adams M.D., Hunkapiller M.W., Myers E.W., Venter J.C. Molecular cloning of the mature NAD(+) -dependent succinic semialdehyde dehydrogenase from rat and human. cDNA isolation, evolutionary homology, and tissue expression.Chambliss K.L., Caudle D.L., Hinson D.D., Moomaw C.R., Slaughter C.A., Jakobs C., Gibson K.M.J. Biol. Chem. 270:461-467(1995) Human succinic semialdehyde dehydrogenase. Molecular cloning and chromosomal localization.Trettel F., Malaspina P., Jodice C., Novelletto A., Slaughter C.A., Caudle D.L., Hinson D.D., Chambliss K.L., Gibson K.M.Adv. Exp. Med. Biol. 414:253-260(1997) Lysine acetylation targets protein complexes and co-regulates major cellular functions.Choudhary C., Kumar C., Gnad F., Nielsen M.L., Rehman M., Walther T.C., Olsen J.V., Mann M.Science 325:834-840(2009) Initial characterization of the human central proteome.Burkard T.R., Planyavsky M., Kaupe I., Breitwieser F.P., Buerckstuemmer T., Bennett K.L., Superti-Furga G., Colinge J.BMC Syst. Biol. 5:17-17(2011) An enzyme assisted RP-RPLC approach for in-depth analysis of human liver phosphoproteome.Bian Y., Song C., Cheng K., Dong M., Wang F., Huang J., Sun D., Wang L., Ye M., Zou H.J. Proteomics 96:253-262(2014) Redox-switch modulation of human SSADH by dynamic catalytic loop.Kim Y.-G., Lee S., Kwon O.-S., Park S.-Y., Lee S.-J., Park B.-J., Kim K.-J.EMBO J. 28:959-968(2009) Prenatal diagnosis of succinic semialdehyde dehydrogenase deficiency increased accuracy employing DNA, enzyme, and metabolite analyses.Hogema B.M., Akaboshi S., Taylor M., Salomons G.S., Jakobs C., Schutgens R.B., Wilcken B., Worthington S., Maropoulos G., Grompe M., Gibson K.M.Mol. Genet. Metab. 72:218-222(2001) Mutation analysis in a patient with succinic semialdehyde dehydrogenase deficiency a compound heterozygote with 103-121del and 1460T>A of the ALDH5A1 gene.Aoshima T., Kajita M., Sekido Y., Ishiguro Y., Tsuge I., Kimura M., Yamaguchi S., Watanabe K., Shimokata K., Niwa T.Hum. Hered. 53:42-44(2002) Mutational spectrum of the succinate semialdehyde dehydrogenase (ALDH5A1) gene and functional analysis of 27 novel disease-causing mutations in patients with SSADH deficiency.Akaboshi S., Hogema B.M., Novelletto A., Malaspina P., Salomons G.S., Maropoulos G.D., Jakobs C., Grompe M., Gibson K.M.Hum. Mutat. 22:442-450(2003)
NCBI and Uniprot Product Information
NCBI GI #
NCBI GeneID
NCBI Accession #
NCBI GenBank Nucleotide #
Molecular Weight
54.3 kDa
NCBI Official Full Name
succinate-semialdehyde dehydrogenase, mitochondrial isoform 2
NCBI Official Synonym Full Names
aldehyde dehydrogenase 5 family member A1
NCBI Official Symbol
ALDH5A1
NCBI Official Synonym Symbols
SSDH; SSADH
NCBI Protein Information
succinate-semialdehyde dehydrogenase, mitochondrial
UniProt Protein Name
Succinate-semialdehyde dehydrogenase, mitochondrial
UniProt Gene Name
ALDH5A1
UniProt Synonym Gene Names
SSADH
UniProt Entry Name
SSDH_HUMAN
Customer Reviews
Loading reviews...
Share Your Experience
Similar Products
Product Notes
The ALDH5A1 aldh5a1 (Catalog #AAA113512) is a Recombinant Protein produced from E Coli or Yeast or Baculovirus or Mammalian Cell and is intended for research purposes only. The product is available for immediate purchase. The immunogen sequence is 48-535. Full Length of Mature Protein. The amino acid sequence is listed below: AGRLAGLSAA LLRTDSFVGG RWLPAAATFP VQDPASGAAL GMVADCGVRE ARAAVRAAYE AFCRWREVSA KERSSLLRKW YNLMIQNKDD LARIITAESG KPLKEAHGEI LYSAFFLEWF SEEARRVYGD IIHTPAKDRR ALVLKQPIGV AAVITPWNFP SAMITRKVGA ALAAGCTVVV KPAEDTPFSA LALAELASQA GIPSGVYNVI PCSRKNAKEV GEAICTDPLV SKISFTGSTT TGKILLHHAA NSVKRVSMEL GGLAPFIVFD SANVDQAVAG AMASKFRNTG QTCVCSNQFL VQRGIHDAFV KAFAEAMKKN LRVGNGFEEG TTQGPLINEK AVEKVEKQVN DAVSKGATVV TGGKRHQLGK NFFEPTLLCN VTQDMLCTHE ETFGPLAPVI KFDTEEEAIA IANAADVGLA GYFYSQDPAQ IWRVAEQLEV GMVGVNEGLI SSVECPFGGV KQSGLGREGS KYGIDEYLEL KYVCYGGL. It is sometimes possible for the material contained within the vial of "Succinate-semialdehyde dehydrogenase, Recombinant Protein" to become dispersed throughout the inside of the vial, particularly around the seal of said vial, during shipment and storage. We always suggest centrifuging these vials to consolidate all of the liquid away from the lid and to the bottom of the vial prior to opening. Please be advised that certain products may require dry ice for shipping and that, if this is the case, an additional dry ice fee may also be required.Precautions
All products in the AAA Biotech catalog are strictly for research-use only, and are absolutely not suitable for use in any sort of medical, therapeutic, prophylactic, in-vivo, or diagnostic capacity. By purchasing a product from AAA Biotech, you are explicitly certifying that said products will be properly tested and used in line with industry standard. AAA Biotech and its authorized distribution partners reserve the right to refuse to fulfill any order if we have any indication that a purchaser may be intending to use a product outside of our accepted criteria.Disclaimer
Though we do strive to guarantee the information represented in this datasheet, AAA Biotech cannot be held responsible for any oversights or imprecisions. AAA Biotech reserves the right to adjust any aspect of this datasheet at any time and without notice. It is the responsibility of the customer to inform AAA Biotech of any product performance issues observed or experienced within 30 days of receipt of said product. To see additional details on this or any of our other policies, please see our Terms & Conditions page.Item has been added to Shopping Cart
If you are ready to order, navigate to Shopping Cart and get ready to checkout.